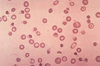

Presentation Dengue fever
- Initial acute phase: Fever, severe headache (retro-orbital pain), malaise, severe joint and muscle pain, N&V
Rash several days after fever onset - Secondary severe phase (3-7 days after sx onset; ~ when fever starts to subside): haemmhoragic shock
- > skin: petechiae, purpura, bruising
- > bleeding from gums, nose, eyes
- > intestinal and other internal bleeding
- > thrombocytopaenia
- > late eosinophilia
Pertussis
‘whooping cough’
bacteria - bordatella pertussis
After 1 to 2 weeks and as the disease progresses, the traditional symptoms of pertussis may appear and include: Paroxysms (fits) of many, rapid coughs followed by a high-pitched “whoop” sound. Vomiting (throwing up) during or after coughing fits. Exhaustion (very tired) after coughing fits
- often whooping cough occurs in 6mo-5 year olds. may be absent in older or younger people
- may be dehydrated with conjunctival or facial petechiae from intense coughing
Live vaccines
Rotavirus
MMR
Varicella
IN influenza
BCG
Travel - yellow fever
Immunology of vaccination
mimic response to infection without severe disease
Vaccine injection -> attracts dendritic cells, monocytes, neutrophils -> activation of those cells following Ag presentation -> migration of those cells to draining lymph node -> in LN you have activation of T and B cells
How do toxin-mediated vaccines work
High yield strain of C tetani is cultured to produce commercial toxoid which is harvested, purified and detoxified -> IgG levels correlate with protection
ex: tetanus
Conjugate vaccines - Mechanism
Benefits
Ex
- A conjugate vaccine is a type of subunit vaccine which combines a weak antigen with a strong antigen as a carrier so that the immune system has a stronger response to the weak antigen.
- Usefully for vaccines against bacteria which are protected by polysaccharide capsule
- (The three most common causes of bacterial meningitis –
- Neisseria meningitidis (the meningococcus A,C,W,Y)
- Streptococcus pneumoniae
- Haemophilus influenzae type b (Hib)
Benefits
- T cell dependent
- high serum levels IgG
- produces long-lasting immune memory
- Decreases carriage which produces broader herd immunity

Generation of B cell memory responses
Generated in response to T-dependent Ag in the germinal centres (spleen/lymph nodes) in parallel to plasma cells.
At their exit, they differentiate into memory B cells that transiently migrate through blood towards extrafollicular areas of spelln and nodes
Persist there as resting cells until re-exposed to their specific Ag
On secondary exposure, memory B cells readily proliferate and differentiate into plasma cells
-> secrete large amt of high affinity Ab that can be detected in serum a few days after boosting

Vaccine side-effects
inactivated vs activated
Inactivated
- SE within 72 hours
- Fever, local reaction
Live attenuated
- Delated side effect
- MMR: 5-14d (peak d10), fever, febrile convulsion (incr risk), rash
- Varicella, rotavirus - fever, vomiting
- Rotavirus -> intussusception (up to 7 days following first vaccine)
Anaphylaxis very rare (1 case per million vaccinated)
Immune compromised individuals - how does this affect the vaccination schedule?
Live vaccines are generally CI as they can cause vaccine-related disease due to replication of the vaccine virus/bacteria
Includes BCG, oral typhoid, yellow fever, MMR, VZV
Rotavirus can be given except in case of intussusception
Household contacts should be vaccinated, incl with live vaccines (MMR, rotavirus)
Tetanus Vaccination schedule
Vaccination
o Immunisations at 2,4,6 months then boosters at 18 months, 4 years and 10-15years
o Need 2x boosters to provide lasting immunity until middle age
o 10 year boosters no longer given but provides indication of how long immunity last (eg if treating someone > 10 years post booster, repeat booster)
o DTPa = childhood vaccine, increased doses of diphtheria and pertussis, dTpa = adult vaccine

Passive vs active immunisation
- Passive immunisation = acquisition of PRE-FORMED antibodies
- Natural: Ab transfer from mo to baby across placenta
- Artificial: for example give HSV, hep B or varicella Ig to a pt after tehy are exposed to try to stop them developing the disease
- Active immunisation = administration of an antigen to stimulate the body’s OWN immune response
- via Infection
- or via immunisation
Types of vaccines
- examples
Effect on immunity
Whole organism vaccines
i. Attenuated (live)
ii. Inactivated (killed) - old pertussis
Subunit
(acellular pertussis, 13vPCV, HiB, HepB)
Recombinant protein (IPV, Hep A+B, Influenza)
Polysaccharide (pneum23V, men polysaccharide)
Conjugated
- Rubella
- HIB
- pneumococcal 13
- Men C
Toxoids (Diptheria, tetanus)
Viral vector (covid-19)
Live vaccines/replicative
- self replicating
- relatively long lasting immunity, mimics natural infx
Inactive/Nonreplicative
- preformed Ag mass
- relatively short lasting immunity, may require boosters
Vaccine adjuvant . what is it?
Traditionally based on whole bacteria (CFA) or bacterial cell walls (IFA)
- Gives danger signal to immune system – stimulates TLR and PRR that turn on the immune response
- Amplifies immune response
What extra vaccines do these patients groups need to obtain?
- Indigenous
- Umnderlying medical conditions
Indigenous - Hep A (12mo), Tb and influenza >6mo
Underling medical conditions - pneumococcal (13v at 6mo, 23v at 4yo), influenza >6mo
Preterm- pneumococcal (13v at 6mo, 23v at 4yo), influenza >6mo, Hep B at 12 mo
*Note- give vaccines at chronological age (without correcting for prematurity)
Largest R out of vaccinatable infectious diseases?
Measles R12-18
Pertussis R12-17
Note
- Covid
–> alpha R 2.5
–> delta 5-7
–> omicron ?10
HPV
- disease
- vaccine
- vaccine schedule
Disease - risk of cervical cancer (high risk is 16, 18)
- most cleared within 12-24 mo but 10% persist
Vaccine is recombinant (virus-like particles) . Does NOT contain viral DNA and cannot cause infection.
3x doses at age 12-13yrs
- ok if immunonocompromgsed
- not if pregnant
Which vaccine is CI in HIV pts regardless of CD4+ count?
BCG vaccine
Typhoid + polio oral live attenuated (use inactivated instead)
Varicella post exposure options
Active immunisation (Varicella vaccine) - for healthy hosts within 3-5 days of exposure if haven’t received the full (2) -dose series.
Passive immunisation (Varicella-specific Ab) - in immunocompromised if haven't received the full dose series OR if bone marrow transplant within 24 months or if requiring immunosuppression or having chronic GVHD
Effect of bone marrow transplant on immunity
- Lose immunity to pathogens which they were previously immunised
- Require immunisation against pneumococcus, HiB, tetanus etc
- Avoid live vaccines for 24mo following HSCT (use inactive vaccines or passive immunisation when possible)
- Live vaccines can be given >24mo following HSCT if there is no immunosuppression or GVHD
Indication for hep A vaccination
Travel to endemic areas in children >1yo
Almost universal seroconversion within 4 weeks of vaccination (repeat testing for seroconversion not indicated)
Single dose provides immunity for at least 1 year
Second dose recommended to prolong duration of protection
Least effective vaccine at providing long-lasting immunity
pertussis
Considerations for vaccination of patients with congenital heart disease
- May have asplenia or functional hyposplenia
- May have associated T cell deficiency
- May have increased risk of deterioration/ collapse following immunisation
Considerations for vaccination of oncology patients for those who have NOT completed primary vaccination vs those who HAVE COMPLETED primary vaccination
NOT completed primary vaccination
o Live vaccines contraindicated
- Those receiving immunosuppressive therapy
- Poorly controlled disease
o Administer to seronegative person 3 months after completion of chemotherapy if in remission
- Defer if recent IVIG
o Inactivated vaccines can be given however immune response suboptimal
COMPLETED primary vaccination
o Given a booster course following completion of treatment
How does the rotavirus vaccine work?
Live attenuated
Rotarix - 2,4 mo (Live attenuated human rotavirus vaccine)
-> Monovalent human G1P1A strain – protects against non-G1 serotypes on the basis of other shared epitopes
vs Rotatec 2,4,6 mo (Live attenuated pentavalent human–bovine reassortant rotavirus vaccine)
Prevents rotavirus gastroenteritis of any severity in 70% of those vaccinated + prevents SEVERE gastro req hospitalisation in 85-100% of those vaccinated
CI if previous history of intussusception or a congenital abnormality that may predispose to intussusception (ie mocker’s diverticulum)